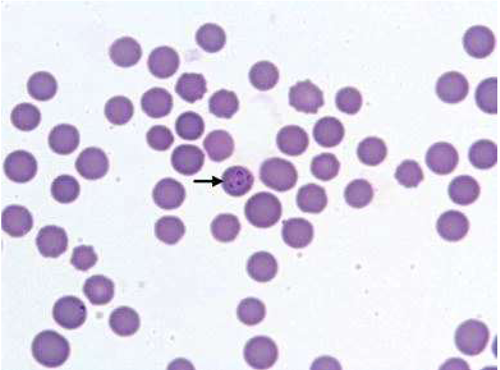

If you have any questions or would like to learn more about our diagnostic services for companion animals, please fill out our Contact Form or call us directly at 011-66-448-448 for prompt assistance and expert support.
VETLAB is a division of ALL VET DIAGNOSTIC SOLUTIONS PVT LTD and providing services of veterinary diagnostic and imaging. The Company is managed by a team of techno professionals. VETLAB venture is now more than 10 years old with multiple centres across India.